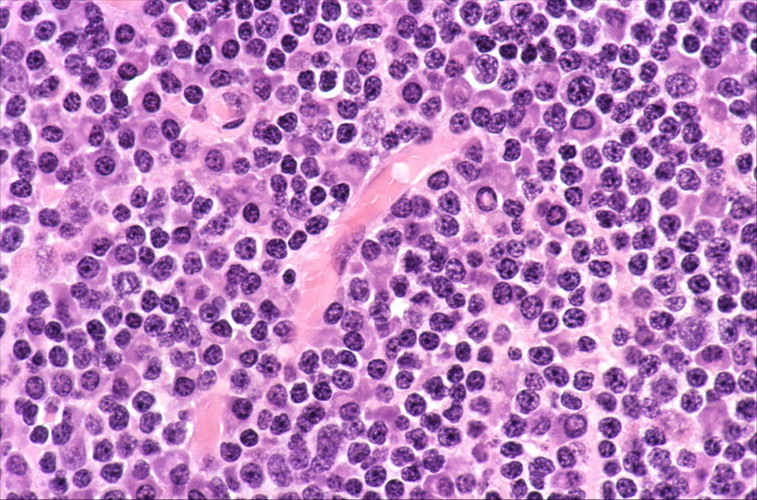
淋巴母细胞瘤

母细胞瘤

微创腹腔镜手术成功切除28天宝宝巨大神经母细胞瘤 - 好大夫在线
图片尺寸1600x1304
病例分享幼女巨大卵巢睾丸母细胞瘤1例
图片尺寸298x343淋巴母细胞瘤
图片尺寸757x500
肾母细胞瘤小儿腹部的定时炸弹
图片尺寸3968x2976
来自皮肤的毛母细胞瘤,手术切除预后良好. - 抖音
图片尺寸600x800血管母细胞瘤haemangioblastoma如何诊断
图片尺寸1080x592
肾母细胞瘤晚期症状
图片尺寸500x760
肝母细胞瘤实体.jpg
图片尺寸1706x1279
小儿神经母细胞瘤
图片尺寸600x866
儿童肝母细胞瘤
图片尺寸500x372
肾母细胞瘤切除术_肾母细胞瘤_肾母细胞瘤治疗方式 - 好大夫在线
图片尺寸1489x1600
4岁女童巨大肾母细胞瘤_肿瘤
图片尺寸2448x3264
肾母细胞瘤小儿腹部的定时炸弹
图片尺寸2976x3968
上海东方肝胆外科医院成功救治低龄巨大肝母细胞瘤患儿
图片尺寸875x663
髓母细胞瘤的手术策略 - 好大夫在线
图片尺寸1030x588
儿童肝母细胞瘤
图片尺寸428x610
haodf:8:xueguanwangzhuangxibaoliu-->血管母细胞瘤 !
图片尺寸1079x1164肾母细胞瘤,光显微镜
图片尺寸1200x800
儿童肾母细胞瘤病理图谱
图片尺寸572x431
肝母细胞瘤_发病原因_症状表现_检查_治疗方式 - 好大夫在线
图片尺寸535x501
猜你喜欢:肝母细胞瘤血管母细胞瘤婴儿肥大细胞瘤图片神经母细胞瘤肾母细胞瘤视神经母细胞瘤母细胞瘤图片骨母细胞瘤神经母细胞瘤患者图片视网膜母细胞瘤 眼睛毛母细胞瘤髓母细胞瘤胶质母细胞瘤软骨母细胞瘤视网膜母细胞瘤胶质母细胞瘤四级视网膜母细胞瘤晚期毛母细胞瘤的图片视网膜母细胞瘤症状视网膜母细胞瘤早期视网膜母细胞瘤图片儿童视网膜母细胞瘤眼睛母细胞瘤晚期图片视网膜母细胞瘤超声视网膜母细胞瘤眼睛眼睛母细胞瘤早期图片神经母细胞瘤死前照片儿童眼睛母细胞瘤图片曹政奭gummy同台照生日寿桃图片姚子羚床战是不是真的钢铁侠脸谱图片练字本电子版摩托罗拉338c掌中宝冷死了表情包下雨天芝麻mochi犬夜叉满天胡明轩手机壁纸个人飞亚达手表价格女士鲈鱼简笔画